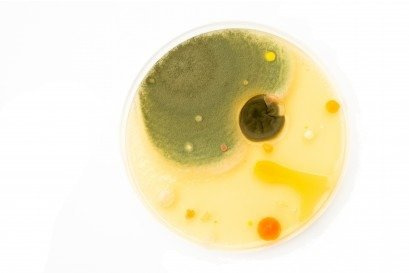
BADANIA NA OBECNOŚĆ GRZYBÓW W ORGANIŹMIE

BADANIA NA OBECNOŚĆ GRZYBÓW W ORGANIŹMIE
- Wybierając ten test otrzymasz wyniki rezonansu na grzyby wymienione poniżej oraz opis informacyjny o możliwościach terapii i profilaktyki.
Grzyby testowane w trakcie diagnostyki
- Alternaria -
- Aspergillus clavatus – kropidlak
- Aspergillus flavus – kropidlak żółty
- Aspergillus fumigatus – kropidlak popielaty- zielonkawy
- Aspergillus Niger – kropidlak czarny
- Aspergillus oryzae – kropidlak żółty
- Aspergillus parasiticus – kropidlak zielony
- Aspergillus repens – kropidlak
- Aspergillus versicolor – kropidlak różnobarwny
- Candida albicans – drożdżak
- Candida glabrata -
- Candida kefir -
- Candida krusei -
- Candida lusitaniae -
- Candida parapsilosis -
- Candida robusta -
- Candida sp. -
- Candida stellata -
- Candida utilis -
- Chrysosporium ST5
- Cladosporium – grzyby pleśniowe
- Cladosporium cladosporioides - alergie
- Cladosporium fulvum -
- Cladosporium herbarum -
- Dermatophytes -
- Fusarium culmorum
- Fusarium moniliforme
- Fusarium solani
- Fusarium sporof. B37
- Geotrichum candidum
- Microsporum canis – grzybica drobnozarodkowa
- Mucor mucedo – pleśniak biały
- Mucor racemosus -
- Mycosis fungoides – ziarniniak grzybiasty
- Penicillium brevicompactum - pędzlak
- Penicillium chrysogenum
- Penicillium commune
- Penicillium dypontii FT17
- Penicillium expansum
- Penicillium notatum
- Penicillium roqueforti
- Pullularia pullulans
- Rhizopus nigricans
- Rhizopus rhizopodiformis
- Saccharomyces cerevisiae
- Sporothrix schenckii
- Strepto+Candida mix (sputum)
Niebezpieczne drożdżaki
Niektóre grzyby z rodzaju Candida są chorobotwórcze i mogą prowadzić do zakażenia organizmu. Szczególnie groźnym gatunkiem jest Candida albicans, który rozwija u człowieka kandydozę – chorobę grzybiczą. Do najczęstszych objawów kandydozy należą dolegliwości trawienne, zaparcia, biegunki oraz wzdęcia. Chorzy na kandydozę miewają także problemy z zaśnięciem, cierpią na bóle głowy, depresje, brak koncentracji czy dolegliwości wzrokowe. Objawem choroby są także spadek wagi lub nadwaga, biały język, zaburzenia hormonalne, nadmierne pocenie się czy kruche paznokcie.
Patogeny grzybów Candida mogą wywoływać kandydozę skórną, błon śluzowych, przewodu pokarmowego, układu oddechowego oraz moczowo-płciowego. Kandydoza może przybierać postać układową oraz rozsianą. W przypadku tej pierwszej komórki grzyba znajdują się we krwi, natomiast w drugiej zajmują organy i narządy wewnętrzne.
Co sprzyja rozwojowi drożdżaków ?
Niektóre grzyby fizjologicznie zasiedlają ludzki organizm, tak jak Candida albicans. Staje się on niebezpieczny dopiero wówczas, gdy jego populacja zaczyna się gwałtownie rozrastać. Ich intensywny rozwój może być spowodowany zanieczyszczeniami środowiska, zwiększoną ilością stosowanych leków i antybiotyków, nadmiernym spożywaniem alkoholu, konserwantami oraz długotrwałym stresem. Badania na grzyby Candida są ważne z tego względu, aby stale kontrolować ich ilość w organizmie.
Jak wyglądają badania na obecność Candida?
Badania na grzyby Candida polegają na wykrywaniu komórek drożdżaka w surowicy krwi żylnej. Podczas testów diagnostycznych są wykorzystywane różne antygeny Candida, jak struktury ściany i błony komórkowej czy białka hsps. Można także wykonać posiew, gastroskopię lub kolonoskopię. Takie badania umożliwiają wykrycie Candida w przewodzie pokarmowym, natomiast trudno jest zdiagnozować grzybicę narządów wewnętrznych. Jednak najszybszym i najdokładniejszym badaniem na grzyby (Candida) jest biorezonans.
Dlaczego warto wykonać badania na grzyby Candida?
Regularny monitoring zagrożonego pacjenta w postaci badań na obecność Candida oraz innych grzybów stanowi istotną informację diagnostyczną. Poza tym, odpowiednia diagnoza i podjęcie właściwego leczenie może raz na zawsze sprawić, że organizm pacjenta osiągnie pożądaną równowagę, a on sam pozbędzie się uporczywych i nieprzyjemnych dolegliwości. Nasze laboratorium diagnozuje poszczególne grzyby z rodzaju Alternaria, Aspergillus, Chrysosporium, Cladosporium, Fusarium, Mucor, Penicillium, Rhizopus i wiele innych. Oferujemy badania na grzyby Candida albicans, Candida glabrata, Candida kefir, Candida krusei, Candida lusitaniae, Candida parapsilosis, Candida robusta czy Candida utilis.